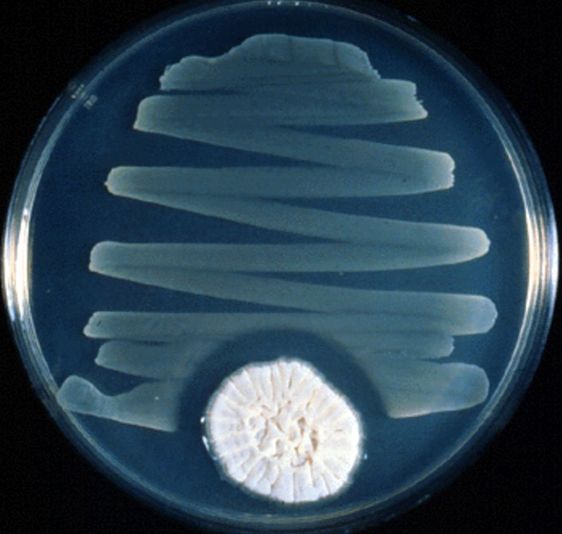

我们会以什么样的价格治愈所有疾病?丨诺奖得主 Aaron Ciechanover 最新演讲
| 导读 | 美国著名经济学家保罗·皮尔泽曾在《财富第五波》一书中指出,健康产业将引发全球“第五波”财富革命,可能取代 IT 业成为未来十年内领导世界经济发展的主要增长点。但这个预言背后的一个隐忧是,对于我们每一个人来说,我们又将付出什么样的“价格”才能治愈疾病? |
美国著名经济学家保罗·皮尔泽曾在《财富第五波》一书中指出,健康产业将引发全球“第五波”财富革命,可能取代 IT 业成为未来十年内领导世界经济发展的主要增长点。
但这个预言背后的一个隐忧是,对于我们每一个人来说,我们又将付出什么样的“价格”才能治愈疾病?
这个话题同样出现在诺奖得主 Aaron Ciechanover 近日的演讲中。8 月 11 日,2004 年诺贝尔化学奖获得者、以色列理工学院杰出教授 Aaron Ciechanover 出席了在京举行的世界科技创新论坛,发表了名为《个性化医学的革命》的演讲。
“在过去,我们用“大炮”攻击疾病,处理上比较粗糙,但现在,我们有了更精细的手段。但是技术的发展还需要很长的时间。因为很多变异的原因和过程我们并不完全了解”,Ciechanover 如此评价眼下的这场个性化医学革命。
在演讲中,他分享了全球三次医药技术发展重要节点,同时也指出了当下的生物医药的三个重点发展方向以及未来的几大挑战,其中就包括对于医疗支出的预言。

图丨 Aaron Ciechanover。2004 年,他和另外两位科学家因“发现了泛素调节的蛋白质降解(一种蛋白质降解的重要机理)”被授予诺贝尔化学奖。值得一提的是,阿龙·切哈诺沃,他也是第一位获得科学类诺贝尔奖的以色列人
以下为 Aaron Ciechanover 演讲全文(经过基于原意的删减和修改):
现在,包括中国在内的很多国家,人们的寿命都已经超过了 80 岁。但几百年以前,人均的寿命只有 50 岁,在 19 世纪末、20 世纪初,平均寿命只有 50-55 岁。
也就是说,短短一百年时间,人均寿命就提升了 30 年。秘密是什么呢?
秘密就是科技的发展,各种因素、各式各样的科技发明,包括手术、饮食、药学、对人体机理的理解、运动以及医院发挥的作用,以及不同国家的沟通、信息共享等等,这些对于人均寿命的提升也非常重要的。还有抗生素的发展,所有的这些因素加在一块,带了这样大幅度的寿命增长。
但这里有两个有意思的问题:首先,这个趋势是否继续,一百年以后,人均寿命是不是会达到150 岁甚至更长?如果达到 150 岁,我们付出的代价是什么?
这个代价非常明确。今天,在很多发达国家,医院里也有很多病人,他们主要遭受三大疾病的困扰——癌症、心血管疾病、脑疾病。
所有的这些疾病都是我们付出的代价。人的寿命越来越长,但这些疾病是我们付出的代价。
一百年前没有多少人死于癌症,不是说那时候当时没有癌症,而是那个时候很多人没有活到受癌症的影响就死去。
再说心脏病,一百年前确实有一部分人死于心脏病。但是,心脏病和癌症都是随着年龄的增长发病率更高,还有脑部疾病,比如说帕金森症、阿尔兹海默症,所有疾病都和年龄有关,年龄越大患病机率越高。
也就是说,人类虽然寿命在延长,但是付出的代价也在增加。而且,我们预计这些疾病会变越来越严重、越来越普遍。科学家现在在这三个疾病上做了大量的研究,比如说心血管疾病,我们取得了很多突破,但对脑部疾病的攻克进程远远落后于另外两个疾病。
那么,我们当下的医学和药学有哪些进展呢?有三个重点发展方向。
第一个方向就是医疗设备,我讲的不是医学图像设备这样的医疗硬件,而是包括人造器官、动脉支架、清除动脉阻塞的小型设备等这样的医疗设备。
第二个发展的方向就是组织工程,比如说干细胞,干细胞就是组织工程的一个分支,还有 还有很多孕妇在生产的时候收集的脐带血,这也被称作是“最好的银行”,是对于未来最好的投资。
第三个就是传统的药物开发,我详细谈一谈药物开发,这其中也有三次革命。

上世纪初,有两个人类最早开发的药物诞生,一个就是青霉素,一个就是阿司匹林,这些药物的开发是偶然发现,青霉素更是对世界产生了革命性的作用。
在此之前,人们不知道有这样的抗生素存在,但 Alexander Fleming 发现了。一次意外,他发现产生青霉素的真菌能够对细菌有抑制作用。随着这种青霉素不断的发展,它可以遏制病毒的存活,之后他对真菌进行提纯,从此开发出来青霉素。
最早药物都是靠偶然的发现,但我们不能再靠这种办法了,我们需要有组织、有系统的开发药物,也就是过去几十年我们采用的办法:50 年代、60 年代、70 年代就是高通量药物筛选,比如可以通过动物实验,提取动物细胞做实验,尝试不同的化合物,你可能不理解药理机制,但是你可以通过几百次的实验不断的试。
对,这里面没有其他的机制,就是试错。我们通过这种方式开发出他汀,用以预防心脏的疾病。在70 年代,他汀成为了一个重磅药,对整个世界产生巨大的影响。
但是,我们能不能用筛选的方法治脑部疾病呢?答案是,不行。
因为人和人有很大的差别,世界上没有两个人是完全一样的,即使是孪生兄弟和姐妹也存在很大的差别,他们的基因也存在差别。由于变异基因的遗传,没有任何两个人是一模一样的,所以,疾病在不同两个人身上也会有不同的反应,基因存在有多态性,有的人健康,有的人不健康,有人活在这个环境中,有的人活在那个环境中,所以每两个人都不一样。
到了 2000 年,下一代药物开发办法出现了,就是对人类基因组进行测序。
90 年代时的基因组测序,对人类基因组进行第一次测序需要花费几十亿美金。这个技术出现的时候,《纽约时报》头版头条报道了,还有很多其他媒体也都在报道。
到现在为止,基因测序已经发展非常快了,现在只要几个小时、三四千美元就可以进行测序,和过去相比,这项技术的成本下降了很多,而且发展处各种各样的方法:动态测序法、固态测序法、电子测序法等等。一个小办公室里面就可以进行测序,解密三四十亿的碱基对,背后还有软件解读。
当然,基因测序也对很多疾病带来了影响。过去,我们可能认为,癌症就是一种疾病,比如乳腺癌就是乳腺癌,但实际上,虽然都叫乳腺癌,每个人背后的基因变异完全不同,也就是乳腺癌出现的原因各不相同。如今,我们发现乳腺癌的成因甚至超过 20 多种。
有了基因测序,我们可以找出究竟患者哪个基因出现了变异,并专门设计一种分子蛋白质来直接的应对这种变异,进而治愈乳腺癌。
在过去,我们用“大炮”攻击疾病,处理上比较粗糙,但现在,我们有了更精细的手段。但是这个技术的发展还需要很长的时间。因为很多变异的原因和过程我们并不完全了解。
随着时间的进展,我们对这方面的研究会越来越深入,我们除了对疾病进行个性化的诊断之外,我们也要个性化的治疗革命。
这场革命首先它速度不会很快,因为它除了是个性化之外,也是预测性的,因为通过基因测序我们可以知道人体内产生了哪一种基因变异,因此可以进行及时的预防。这就是未来医学的几个特点:个性化、预测性、预防性、参与性(病人对于自己的 DNA 有深入的了解)。

我们会遇到挑战,无论是技术方面,还在伦理道德方面。例如,有些疾病并不那么简单,比如新陈代谢疾病和精神病,精神病对于家庭带来的经济和精神负担是最重的,它可能是由于多个基因导致的,我们却不知道具体是哪些基因。还有代谢疾病,它也是由于多个基因变异导致的。这是第一个挑战。
而有些疾病,尤其是癌症,它可能会影响我们做出错误的判断。癌症病人的基因是不稳定的。它可能会逐渐地产生抗药性,会形成第二次、第三次的变异。所以,病人可能一开始接受治疗的时候会有效果,但是第二次再进行治疗的话,它的效果就小了,这就是肿瘤在变异。

还有一点就是价格。对我们来说,价格就是实实在在的真金白银。而未来个性化医疗的价格会比现在更高,因为很多疾病将被分解成小的个性化疾病方向进行诊断,这样一来,药物开发的成本大幅上涨,现在就有很多药企面临巨大的挑战。但这就是科学前进的方向,最终的结果对人类而言肯定是乐观。
未来医疗将更加精准化,更能够治愈更多的疾病,更加有效,同时副作用更小。(转化医学网360zhyx.com)
 腾讯登录
腾讯登录
还没有人评论,赶快抢个沙发